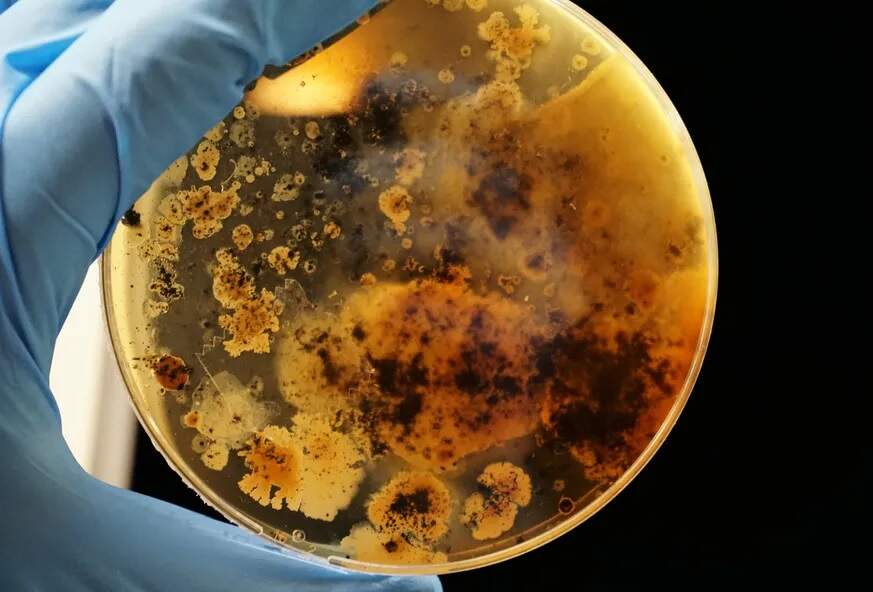

Domingo, 22 de Março de 2026
Domingo, 22 de Março de 2026
Por Redação Rádio Pampa | 17 de setembro de 2024
Mais de 39 milhões de pessoas em todo o mundo podem morrer diretamente devido a infecções resistentes aos antibióticos nos próximos 25 anos, segundo um estudo publicado na noite de segunda-feira (16) pela revista científica The Lancet, que considera possível evitar essa tragédia.
Espera-se que a resistência aos antibióticos, reconhecida como um grande desafio de saúde pública, se agrave nos próximos anos. Esse fenômeno ocorre quando bactérias ou outros patógenos sofrem alterações que os impedem de responder aos tratamentos antimicrobianos.
O estudo avalia, pela primeira vez, o impacto da resistência aos antibióticos ao longo do tempo e tenta calcular sua evolução. De 1990 a 2021, mais de um milhão de pessoas em todo o mundo morreram a cada ano devido à resistência aos antibióticos, de acordo com os autores.
Os pesquisadores analisaram 22 patógenos, 84 combinações entre patógenos e tratamentos, 11 síndromes infecciosas em pessoas de todas as idades em 204 países e territórios, com base em dados de 520 milhões de pessoas.
Resistência
As mortes de crianças menores de cinco anos diretamente causadas pela resistência aos antibióticos diminuíram em mais de 50% em três décadas, pois a prevenção e o controle das infecções melhoraram em bebês e crianças pequenas.
No entanto, as mortes de adultos com 70 anos ou mais aumentaram em mais de 80% nesse período, devido ao rápido envelhecimento da população e à maior vulnerabilidade dos idosos às infecções. Em relação aos patógenos, as mortes causadas pelo Staphylococcus aureus são as que mais aumentaram no mundo.
Nas próximas décadas, as mortes provocadas pela resistência aos antibióticos crescerão ainda mais. O número de vítimas diretas pode chegar a 1,9 milhão anual em todo o mundo até 2050, um aumento de 67% em relação a 2021, segundo as projeções dos pesquisadores.
De acordo com os cientistas, a resistência aos antibióticos pode causar diretamente mais de 39 milhões de mortes no mundo e estar associada a 169 milhões de óbitos entre os anos de 2025 e 2050. Com um melhor tratamento das infecções e acesso a antibióticos, seria possível evitar 92 milhões de mortes no mundo durante esse período, especialmente no sudeste asiático e na África subsaariana, segundo os autores do estudo.